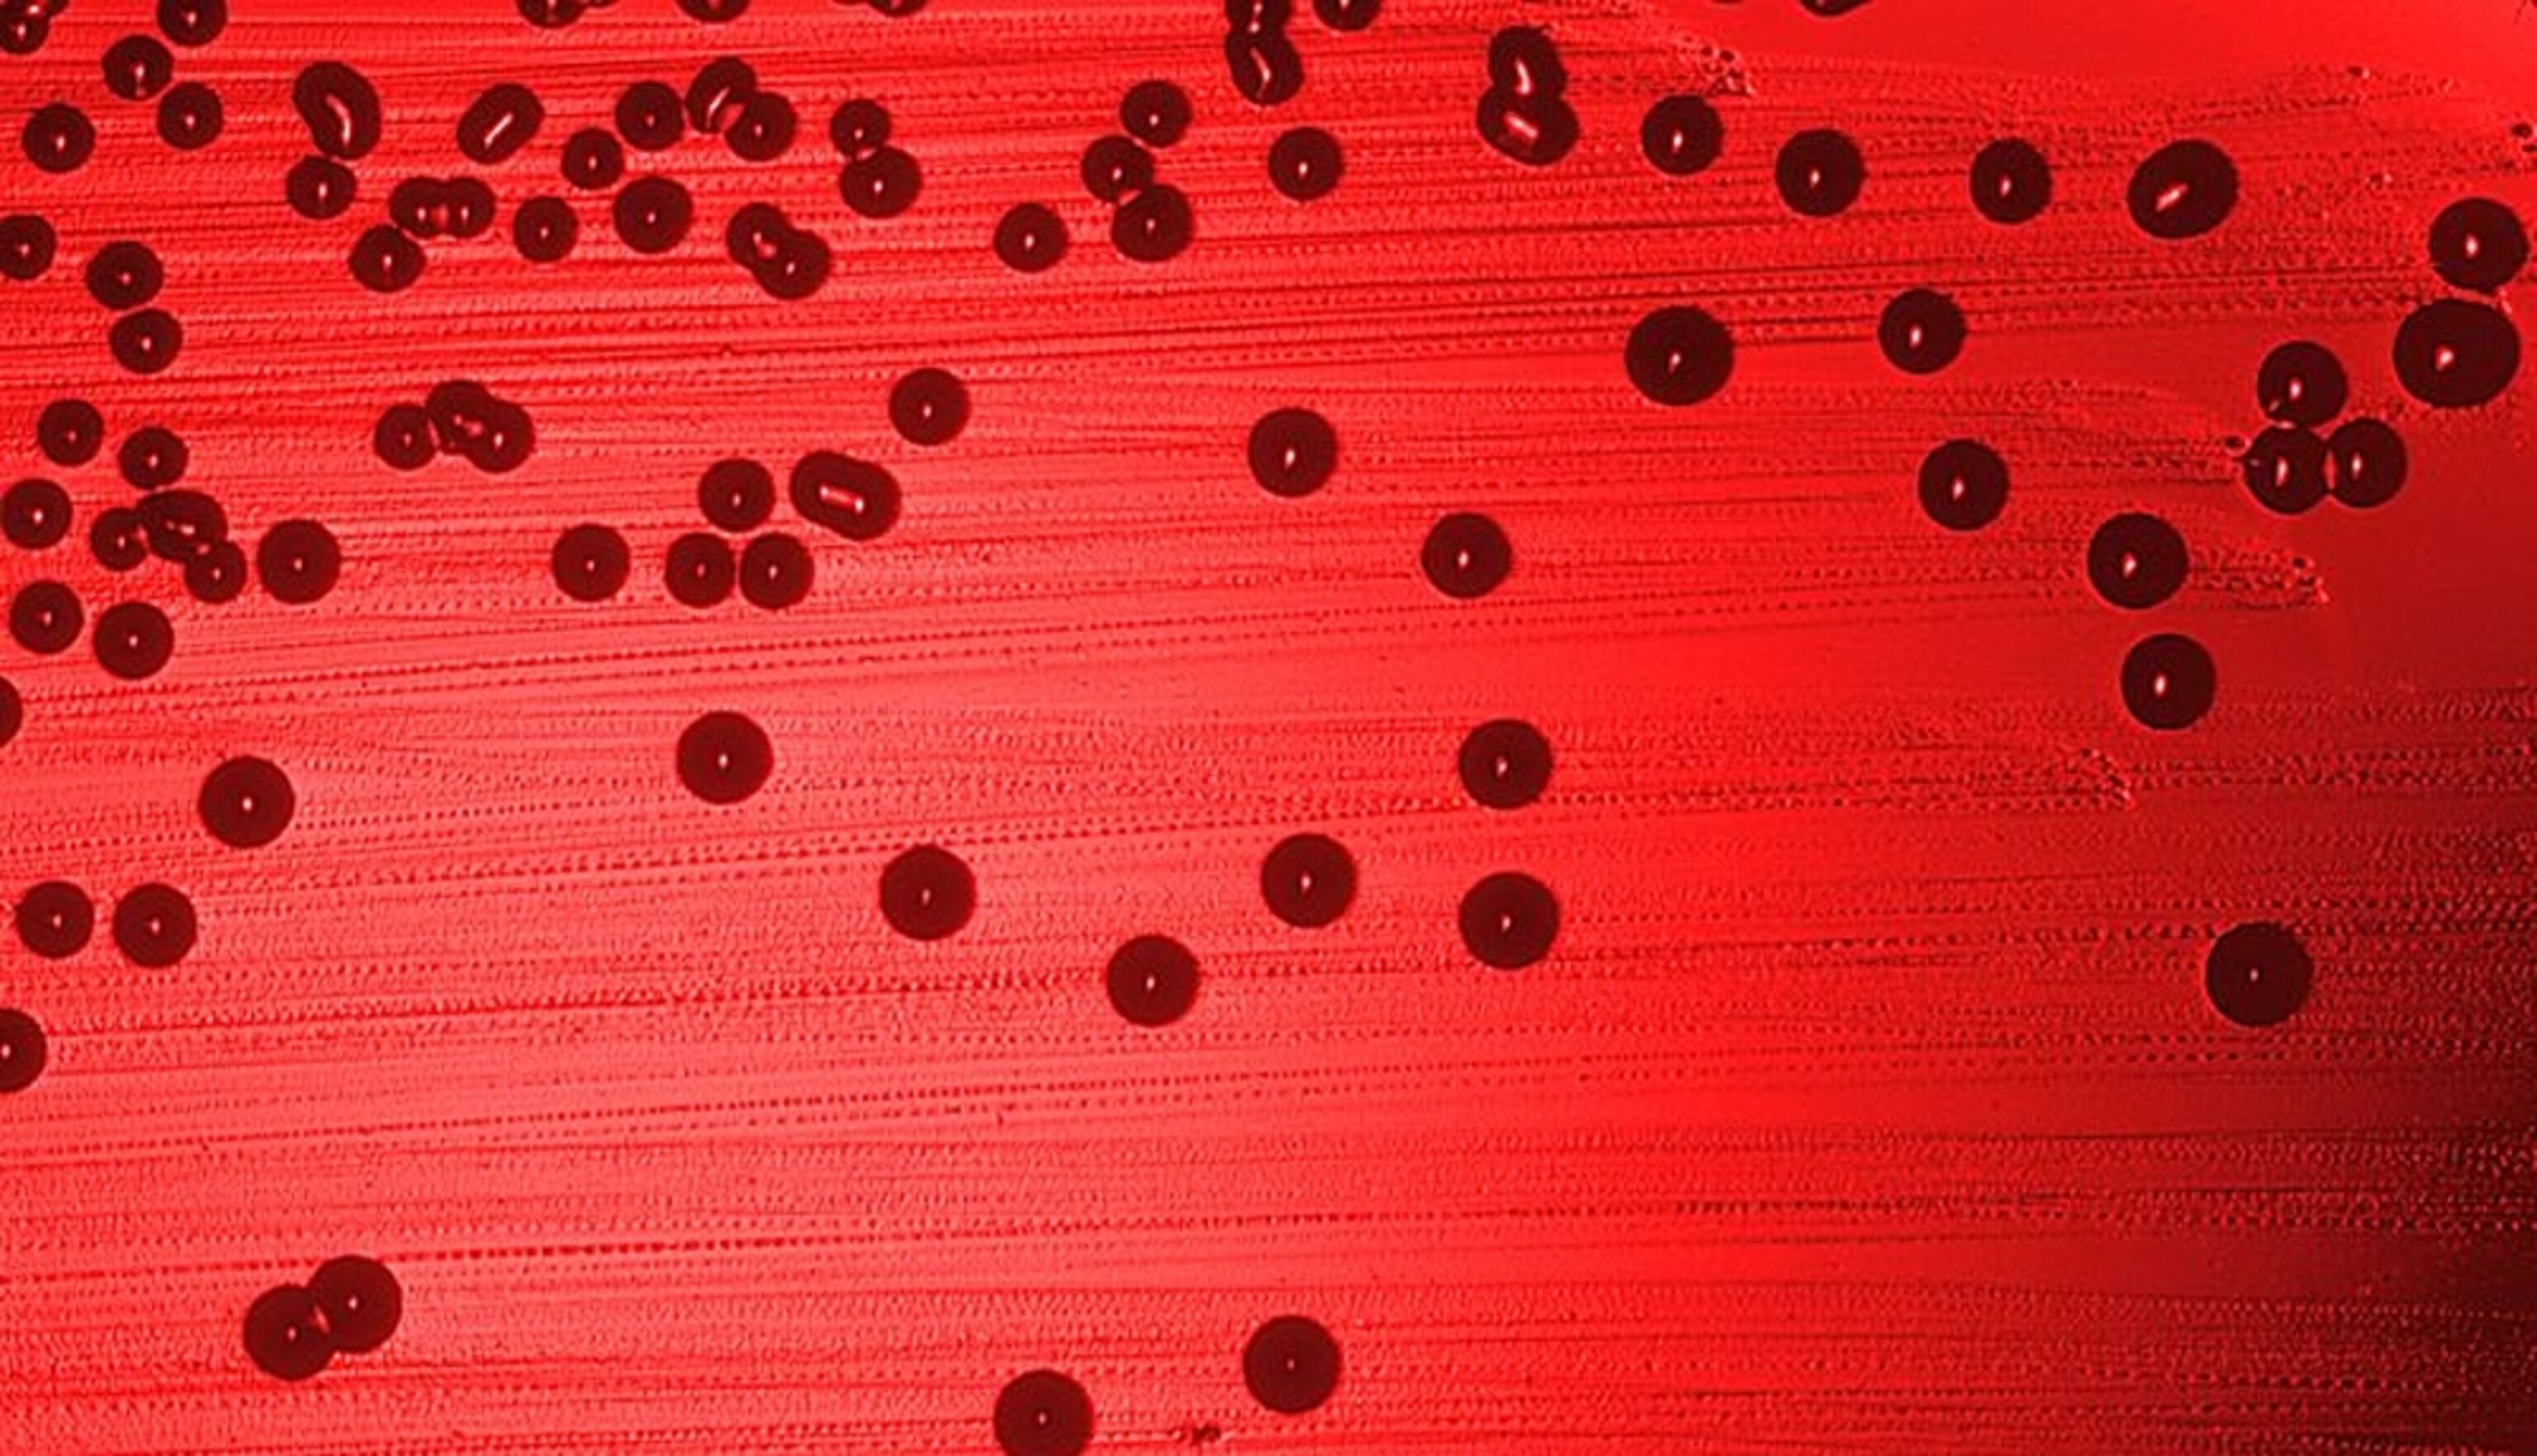

Death by Coincidence
Some human diseases are caused by microbes that have become infectious through evolutionary accidents. They didn’t evolve to infect us, and to reproduce at our expense. Instead, they evolved to fend off competitors or predators or to survive in harsh environments. And by coincidence, the adaptations that help gained make them better at harming our health. For example, a thick coat that stops a microbe from being digested by hungry amoebae might also protect it from our immune system.
This is the coincidental evolution hypothesis, and it’s the subject of my new feature in Aeon. Check it out.
When microbes aren’t killing us, we are largely oblivious to them. So, we construct narratives of hosts and pathogens, heroes and villains, us and them. Those that cause disease exist to reproduce at our expense, and we need new ways of resisting them. And so we study how they evolve to outfox our immune system or to spread more easily from one person to another. We identify genes that allow them to cause disease and we label those genes as ‘virulence factors’. We place ourselves at the centre of their world. We make it all about us.
But a growing number of studies show that our anthropocentric view is sometimes unjustified. The adaptations that allow bacteria, fungi and other pathogens to cause us harm can easily evolve outside the context of human disease. They are part of a microbial narrative that affects us, and can even kill us, but that isn’t about us. This concept is known as the coincidental evolution hypothesis or, as the Emory University microbiologist Bruce Levin described it in 2008, the ‘sh*t happens’ hypothesis. It tells us that at least some human diseases have nothing to do with us at all.